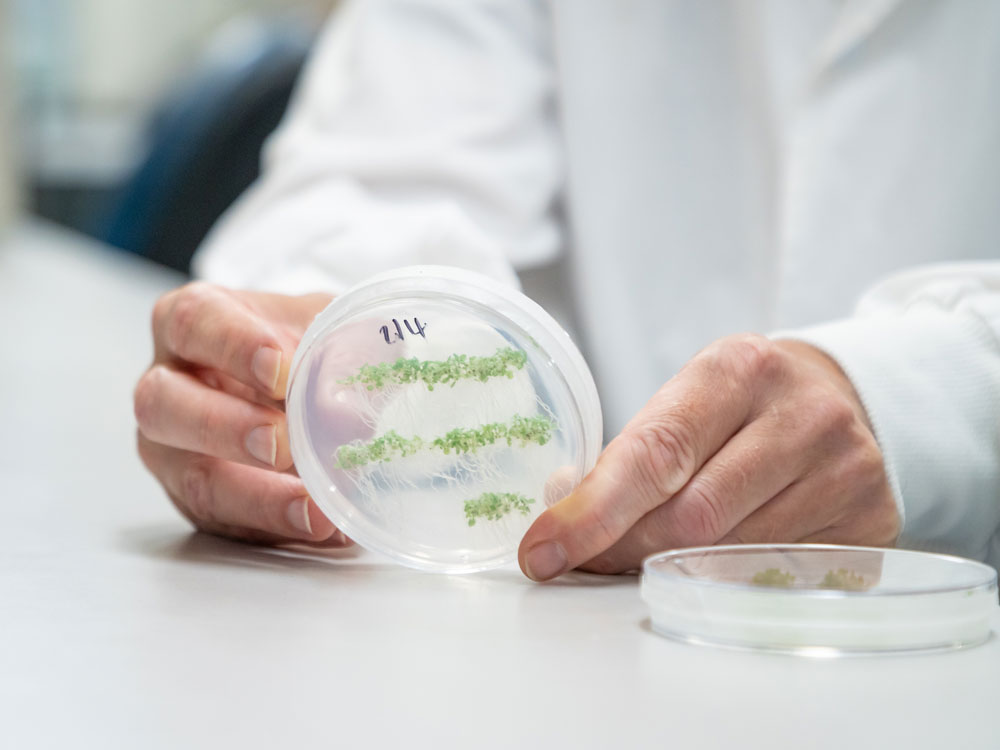
Image: Megan Pope, UQ.

News release
From:
University of Queensland research has revealed that double-stranded RNA-based biopesticides (dsRNA) sprayed on plant leaves can travel right down into root systems.
Led by Dr Chris Brosnan at UQ’s Queensland Alliance for Agriculture and Food Science, the work also disproves a long-standing misconception that dsRNA directly enters plant cells.
“Instead, we have shown in multiple species that when it’s sprayed on a plant’s leaf, the dsRNA is mobile, travelling between cells and throughout the plant, including to the roots,” Dr Brosnan said.
“If we are trying to target a pathogen, then this spray technology has a real chance of being effective, because the dsRNA can move systemically, encountering pathogens to kill.”
dsRNA is a molecule that can regulate genes or trigger RNA interference (RNAi) in target pest and pathogen species, including viruses, bacteria and fungi.
RNAi-based biopesticides are an emerging technology representing a sustainable alternative to synthetic chemical-based crop protection strategies.
When pests or pathogens eat or absorb the dsRNA, essential genes are shut down killing the pest while not causing harm to the plant or any other beneficial or non-target organism.
QAAFI’s Dr Donald Gardiner said the findings were significant.
“This work changes the dogma around the stability, uptake and movement of dsRNA which is vital as we develop the technology,” Dr Gardiner said.
“Currently, there are no effective sprayable products to target pests and pathogens below the ground.
“It’s a challenge to get anything protective into plant roots, so if we can spray RNA on a leaf and get it to move through the plant’s tissues as an intact molecule to its roots, that’s a significant opportunity to target hard-to-reach pests and pathogens.”
Dr Brosnan said the team’s next target was to identify root-based organisms highly susceptible to dsRNA.
“One of the challenges in developing effective RNA-based technologies is the instability of RNA in the soil environment,” he said.
“Our finding could mitigate this problem, but we need to know how this translocated RNA is then transferred to susceptible organisms.
“One target could be nematodes, which are a major pest in agriculture, affecting grains, cotton and many important horticultural species.”
The research was published in Nucleic Acids Research.
This research was supported by the Genome Innovation Hub at UQ, the Australian Research Council Translational Research Hub for Sustainable crop protection from the Australian Government, as well as support from an Advance Queensland Industry Research Fellowship from the Queensland Government. The Queensland Alliance for Agriculture and Food Innovation is a research institute at The University of Queensland, established with and supported by the Department of Primary Industries.
Images are available via Dropbox.



 Australia; QLD
Australia; QLD